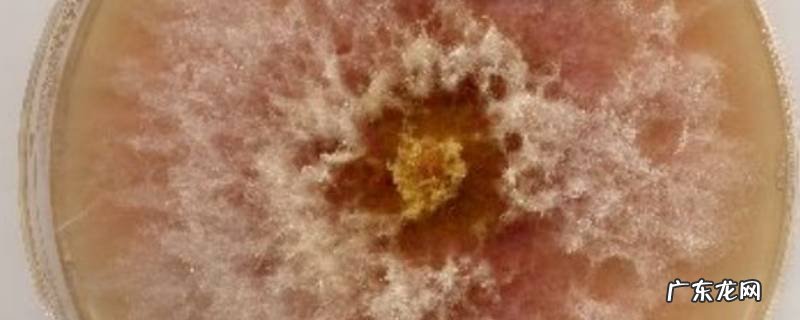

文章插图
【霉菌的特点是什么? 科学 霉菌的特点】
霉菌的菌丝分为两类,即无隔膜菌丝和有隔膜菌丝 。在固体培养基上,营养菌丝是伸入培养基内吸收营养成分的部分菌丝;生长向空气中的菌丝为气生菌丝、而气生菌丝发育到一定阶段,将会成为繁殖菌丝 。霉菌的细胞壁的主要成分为多糖,低等霉菌为纤维素,高等霉菌为几丁质 。这种区别可以用于霉菌的分类鉴定,细胞壁组分的分析是鉴定最重要的依据之一 。霉菌的细胞壁可以被蜗牛酶消化,获得原生质体 。
- 梦见死人在哭什么意思 梦见死了的人在哭是什么意思是什么
- 凉拌海草的做法过程 凉拌海草的做法
- 会计基础是什么 企业的会计基础是什么
- 痔疮是怎么形成的
- 抖音怎么改好友备注名字 抖音里怎么改好友的备注名
- min是什么意思的缩写 min是什么意思
- 华为手机图标怎么恢复原样 华为手机图标恢复原来的样子
- 宸字取名的寓意男孩 宸字取名的寓意
- 传闻中的陈芊芊什么播出 传闻中的陈芊芊什么播出的
- 618是什么节日 干啥的 618是什么节日
特别声明:本站内容均来自网友提供或互联网,仅供参考,请勿用于商业和其他非法用途。如果侵犯了您的权益请与我们联系,我们将在24小时内删除。
